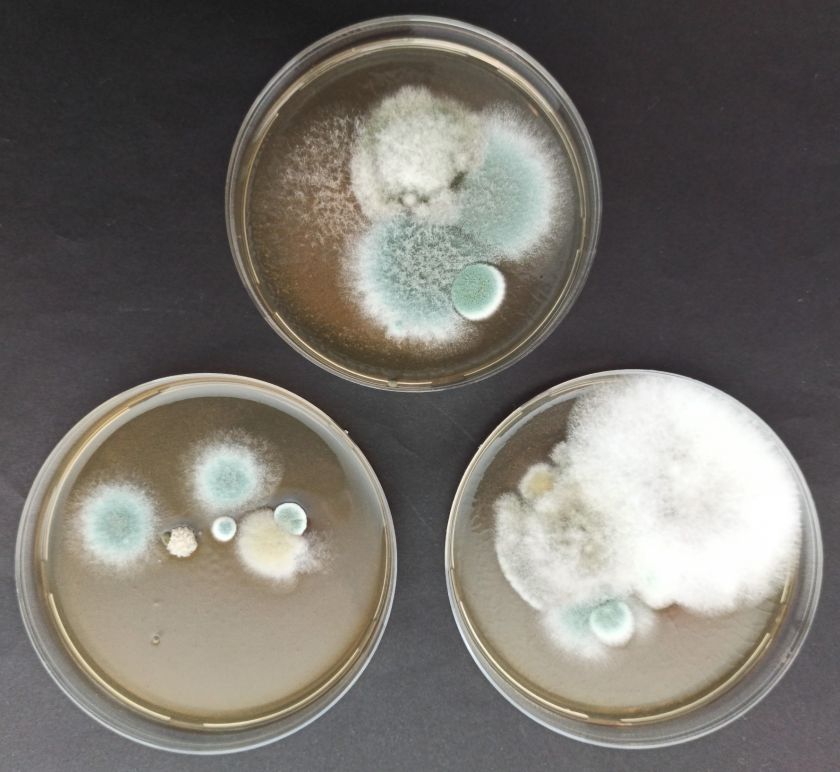

Ar kaskart, įsidūrus spygliu darže ar užmynus ant menkos vinies, kreipiamės į specialistus? Kauno klinikų Šeimos medicinos klinikos šeimos gydytoja Jolanta Sauserienė teigia, kad sunerimti reiktų tiems, kurie paskutinį kartą skiepijosi nuo stabligės daugiau nei prieš 10 metų. „Vakcina nuo stabligės leidžiama kartu su vakcina nuo difterijos. Tai itin pavojingos, sunkios, bet, deja, primirštos ligos“, – sako šeimos gydytoja.
Kas yra difterija ir stabligė?
Difterija – bakterijų – difterijos lazdelių, sukeliama infekcinė liga. Šią ligą dažniausiai sukelia Corynebacterium diphtheriae, kuri išskiria itin stiprų toksiną – nuodus, pažeidžiančius daugelį vidaus organų. Liga gali būti mirtina.
Stabligė – Clostridium tetani bakterijos sukeliama liga. Patekusios į gilią žaizdą, šios bakterijos gamina toksiną, kuris sukelia raumenų spazmus. Jie gali būti tokie stiprūs, kad lūžta žmogaus kaulai, dantys, sutrinka kvėpavimas. Net ir laiku pradėjus tinkamą gydymą, daugelis žmonių neišgyvena.
Kaip šiomis ligomis žmogus gali užsikrėsti?
Difterijos bakterija perduodama oro lašeliniu būdu, kontaktuojant tiesiogiai ar per buities daiktus. Užsikrėsti galima ir nuo besimptomių bakterijos nešiotojų. Liga paprastai pasireiškia po 1-10 dienų nuo užsikrėtimo.
Stabligės sukėlėjas – sporas sudarančios bakterijos, kurios mums pavojingos tik patekusios į gilią žaizdą. Šios sporos itin atsparios aplinkos poveikiams, dirvožemyje gali išlikti gyvybingos ilgus metus. Pačios pavojingiausios yra durtinės, užterštos žaizdos. Svarbu pabrėžti, kad jeigu esame sveiki, neturime kūno žaizdų, stablige nuo sergančiojo neužsikrėsime – suvalgytos ar įkvėptos Clostridium tetani sporos ligos žmogui sukelti negali.
Kokie šių ligų simptomai? Ar jie visada pastebimi?
Difteriją galima įtarti, kai kartu su bendrais anginą primenančiais simptomais, pacientas skundžiais smaugimo jausmu, o apžiūrint sergančiojo ryklę matosi gausios pilkos spalvos apnašos – plėves ant tonzilių ir gomurio. Apie šią ligą visada pagalvojame, kai gydome neskiepytus, užsienyje besilankiusius pacientus, kuriems pasireiškė į anginą panašūs simptomai.
Stabligė įtariama, jei pacientui pasireiškė ir progresuoja raumenų spazmai, kūne yra sužalojimų, dėl kurių nesikreipė į gydymo įstaigą bei nėra paskiepytas ar laiku revakcinuotas.
Koks gydymas skiriamas?
Abiejų ligų atvejais labai svarbus ankstyvas ligos diagnozavimas ir pradėtas gydymas antibiotikais. Visada šiomis ligomis sergantieji yra gydomi ligoninėje, dažnai ir intensyvios terapijos skyriuje, kur taikomas kompleksinis gydymas. Nustačius difterijos ligos atvejį, gali būti taikomas gydymas antibiotikais ir kontaktą turėjusiems asmenims.
Kaip galime apsisaugoti?
Geriausiai nuo šių ligų apsisaugoti padeda vakcinacija. Lietuvoje vaikai skiepijami nuo abiejų ligų pagal skiepų kalendorių, suaugę asmenys – valstybės lėšomis revakcinuojami kas 10 metų. Iki šiol pavyko išvengti difterijos protrūkių Lietuvoje, vakcinacijos aprėptys siekė minimalią ribą, kuri būtina visuotiniam imunitetui išlaikyti. Tačiau pastaruoju metu vaikų imunizacija nėra pakankama, protrūkiai buvo stebėti Latvijoje, kai kuriuose Vokietijos regionuose. Dar prieš COVID-19 pandemiją buvęs tymų protrūkis Lietuvoje leidžia manyti, kad ateityje galime tikėtis ir difterijos atvejų pagausėjimo.
Stabligės visuotinio imuniteto nesukursime – dėl šios ligos esame atsakingi patys. Šiuo metu efektyviai veikia visuotinė priemonė, kai asmuo dėl sužeidimo kreipiasi į gydymo įtaigą. Paprastai yra paskiepijamas kombinuota vakcina nuo difterijos ir stabligės, bei esant užterštai, giliai žaizdai, suleidžiamas ir antitetaninis serumas.
Vakcinos efektyviai apsaugo nuo ligų, yra saugios, daug metų naudojamos visame pasaulyje. Norint pasiskiepyti ar revakcinuotis turite kreiptis į savo šeimos gydytoją arba slaugytoją.
Kauno klinikų informacija
Pranešimą paskelbė: Jovita Gudelevičiūtė, Lietuvos sveikatos mokslų universitetas